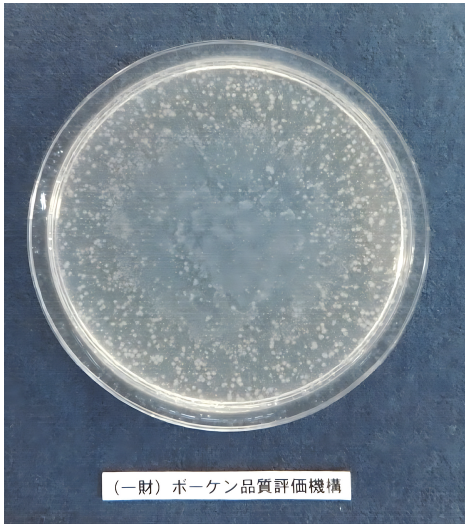
添加された細菌

SIAAマーク認証取得済商品とは?
SIAAマークとは、抗菌・抗ウイルス・防カビ製品の安全性と確かな機能性を第三者機関が厳格に審査し、「効果がきちんとある」「人体に安全」「表示が適切」の3条件をすべて満たした製品だけに付与される、消費者が安心して機能性製品を選ぶための信頼の目印マークです。
-
- フロアコーティング層に付着した細菌の増殖を抑制し長期間、菌を増やさない様にします。細菌の増殖を抑えることができるので衛生的に保つ事が出来ます。
-
- フロアコーティング層に付着した特定ウイルスの数を減少させ長期間効果を発揮します。特定ウイルスの数を減少できるので清潔に保つ事が出来ます。
-
- フロアコーティング層に付着した特定のカビ菌の育成を長期間、抑制する効果を発揮します。不衛生の原因となるカビによる被害を最小限にすることができます。
「エビデンス」の確認にありました。